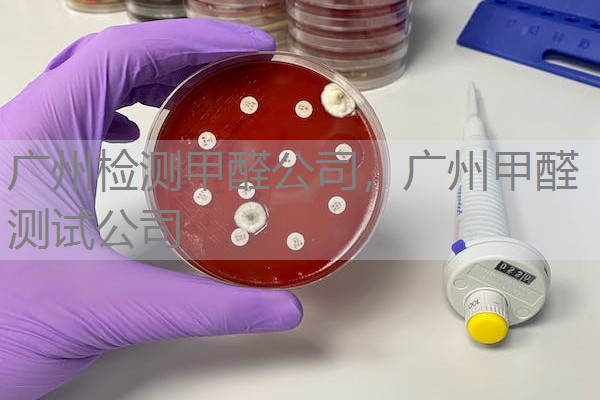

- 深圳门诊空气卫生检测报告 CMA资质检测报告 专业第三方检测公司
- 2025-11-19谢敏
- 广州检测甲醛公司,广州甲醛测试公司
- 2025-11-14深圳华锦检测技术有限公司

- 深圳工厂三废检测报告 废水废气噪声CMA检测报告
- 2025-11-06谢敏

- 室内环境检测项目标准(推荐收藏)
- 2024-04-21科邦检测集团有限公司

- 室内空气污染检测治理公司
- 2024-04-21中国建材检验认证集团股份有限公司

- 香烟烟雾和二手烟污染测试
- 2024-04-21 浙江中通检测科技有限公司

- 杭州室内空气检测机构哪家好,选杭州杭美
- 2024-04-21杭州杭美质量技术服务有限公司

- 工业废气检测:南通工业废气排放检测公司上海有吗?
- 2024-04-21上海德诺产品检测有限公司

- 空气质量检测 深圳甲醛 等上门检测
- 2024-04-21深圳赛德检测技术有限公司

- 山东中安生物安全检测有限公司(空气质量检测)
- 2024-04-21山东中安生物安全检测有限公司

- 东莞环境检测|专业第三方检测|东莞市大成环境检测有限公司
- 2024-04-21东莞市大成环境检测有限公司

- STC - 挥发性有机物及甲醛现场检测服务
- 2024-04-21香港标准及检定中心
空气质量监测
空气检测介绍:
这个行业近年来不断的发展,这个是针对于室内装饰装修、家里新添置东西导致的房间内的空气污染物超标的问题。可以进行行列的分析并且知道整个技术。这个是具有法律效应的。室内空气检测依据室内的空气标准才能够断定整个的污染状况,能够进行合理的防护控制措施。
空气检测为什么如此重要:
洁净的环境是我们生活中的主要场所,我们的生活中离不开空气,那么空气是否合理十分重要,长期的暴露在有污染的空气的环境中污染物会堆积在我们的身体内。空气污染的种类还是比较多的,有物理污染、化学污染、生物污染、放射性污染等。空气质量监测势在必行。
空气检测中甲醛的危害:
甲醛是新房装修中很重要的部分,甲醛的主要危害表现是对于皮肤的黏膜的刺激作用还是很大的。甲醛是原浆的毒物质,能够和蛋白质结合,会对于呼吸道造成一个很严重的刺激,甚至会出现病变的问题。